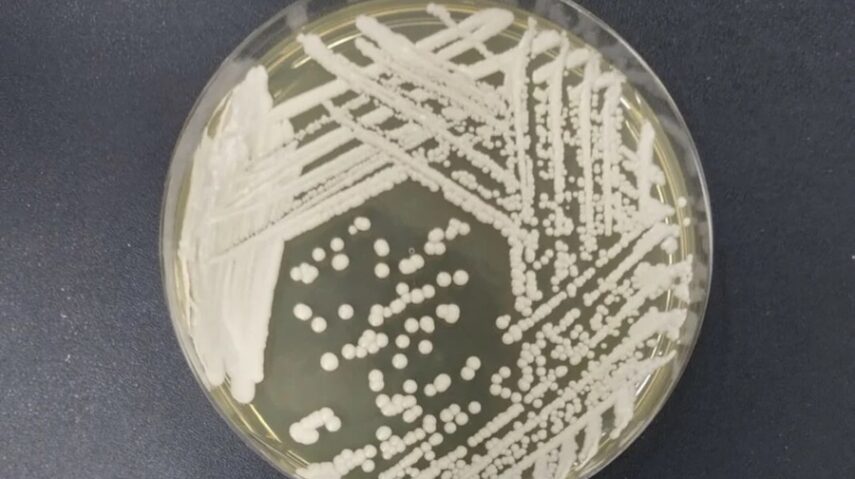

O sequenciamento genético realizado em São Paulo confirmou a amostra do fungo Candida auris identificada em um paciente internado em Natal. A informação foi repassada nesta quinta-feira (5) pela Secretaria de Estado da Saúde Pública do Rio Grande do Norte (Sesap). O resultado do exame especializado reforça o diagnóstico que já havia sido confirmado anteriormente pelo Laboratório Central de Saúde Pública do RN (Lacen/RN), no final do mês de janeiro.
O envio da amostra para análise genética em outro estado faz parte do fluxo nacional de vigilância adotado para a identificação definitiva do fungo, conforme definição do Ministério da Saúde. À epoca da confirmação do caso, o paciente estava internado no Hospital Central Coronel Pedro Germano (Hospital da PM).
A Sesap informou que o paciente segue internado, em quadro clínico estável, e está sendo tratado da condição de saúde prévia que motivou a internação. De acordo com a secretaria, não há manifestação de sintomas associados ao Candida auris.
O Candida auris é considerado um microrganismo de alto risco no ambiente hospitalar por sua resistência a antifúngicos e pela capacidade de permanecer viável por longos períodos em superfícies. Por esse motivo, casos suspeitos ou confirmados demandam monitoramento rigoroso e comunicação imediata às autoridades sanitárias.
No Brasil, o primeiro caso de Candida auris foi registrado na Bahia, em 2020, quando um surto hospitalar resultou na contaminação de 15 pacientes. Desde então, o fungo foi identificado em outros estados. Dados da Agência Nacional de Vigilância Sanitária (Anvisa) apontam que, entre 2020 e novembro de 2025, foram registrados 22 surtos e 134 casos no país.
Tribuna do Norte